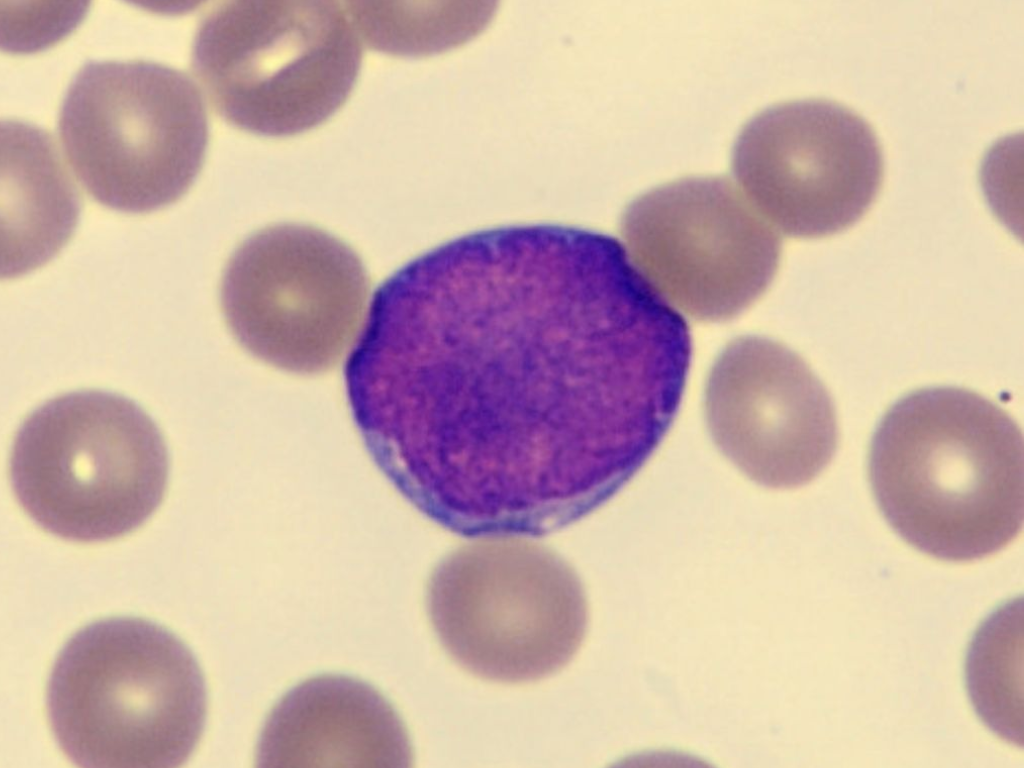
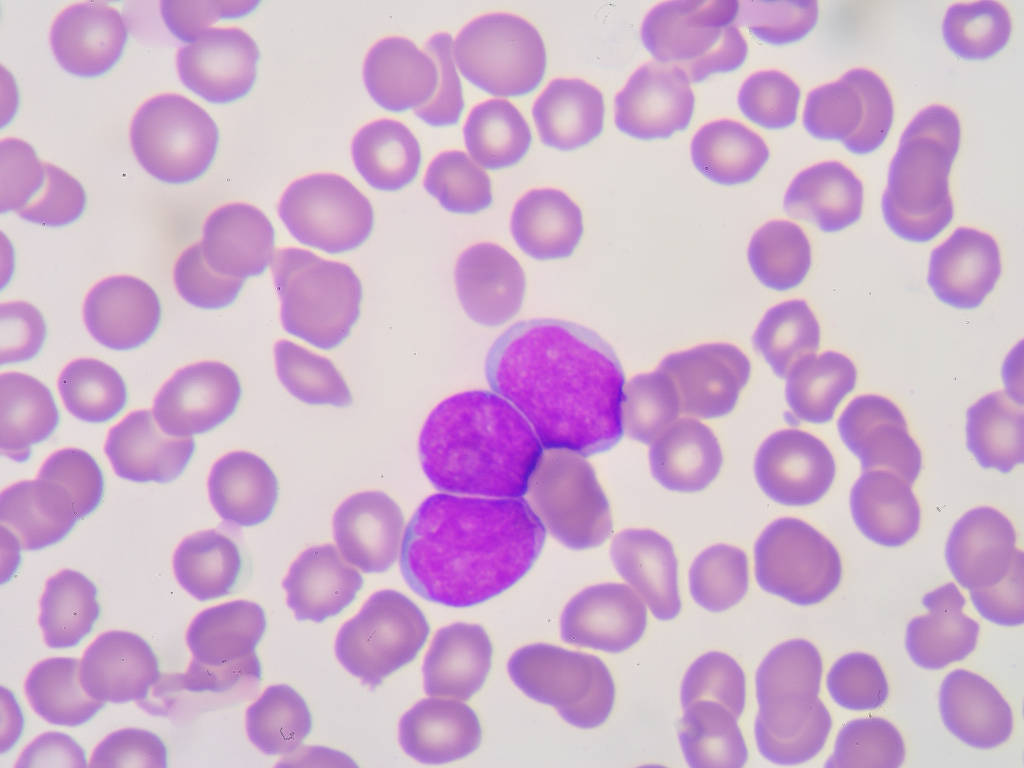
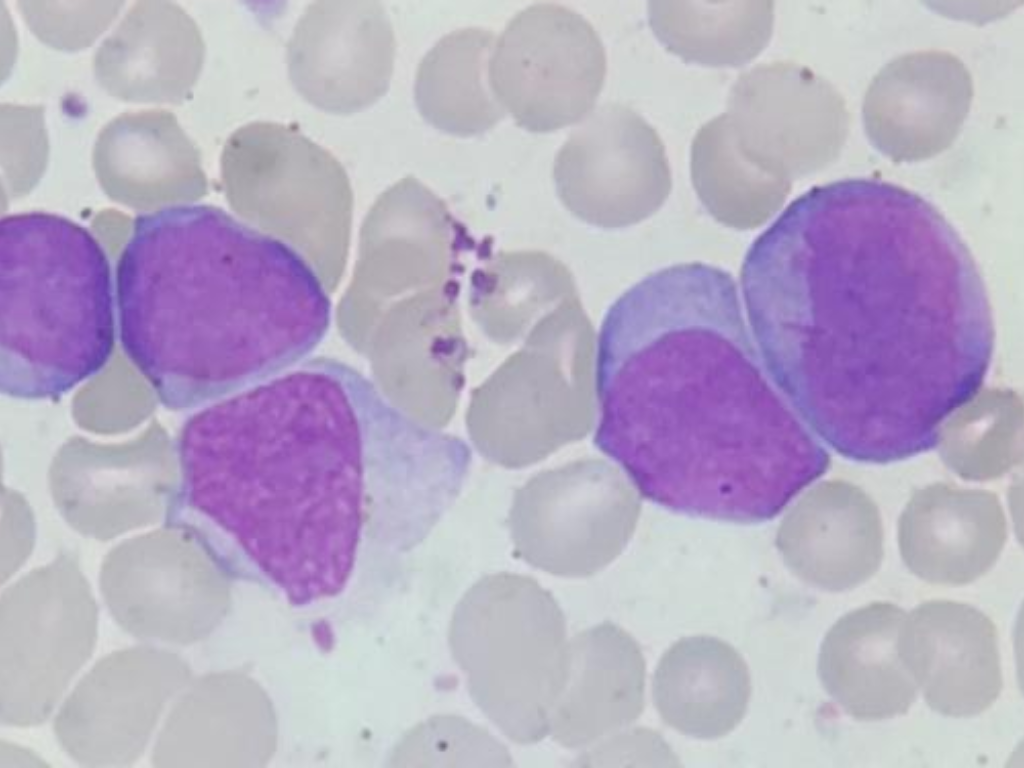

16 de Fevereiro
às 19:00

biomédicos, biólogos, farmacêuticos, médicos e estudantes dessas áreas

com certificado de participação a todos os alunos

O valor desse curso é R$97, você pode comprar seu ingresso ou participar do sorteio e concorrer a uma vaga!
tudo sobre as Leucemias Agudas e se destacar no laboratório!

O valor desse curso é R$97, que pode ser parcelado em até 12 meses.
Para que dinheiro não seja um problema, decidimos sortear algumas vagas.
Para concorrer a uma vaga, preencha o formulário abaixo. Caso você seja sorteado, entraremos em contato.

fundada em 2019 pelo Prof. Dr. Luiz Arthur Calheiros Leite, a Escola Brasileira de Hematologia Laboratorial (LaHemato EaD) já compartilhou conhecimento com mais de 5.000 alunos do Brasil e exterior, em mais de 10 diferentes cursos da área laboratorial.